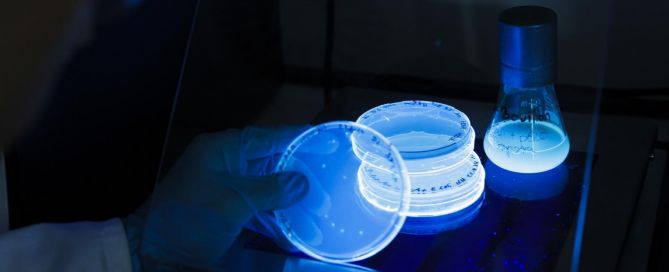

Absolventen der Kilian-von-Steiner-Schule feiern ihren Abschluss
An der Kilian-von-Steiner-Schule in Laupheim haben Schülerinnen und Schüler verschiedener Fachrichtungen ihre Abschlusszeugnisse erhalten. Im kaufmännischen Berufskolleg 1 (BK 1) sowie in der naturwissenschaftlichen Abteilung wurden Chemisch-Technische Assistenten (CTA) und Biotechnologische Assistenten (BioTA) feierlich verabschiedet. Matthias Kugelmann, Klassenlehrer der BioTA, lobte die Absolventinnen und Absolventen bei der Abschlussfeier: „Ihr seid eine tolle Klasse